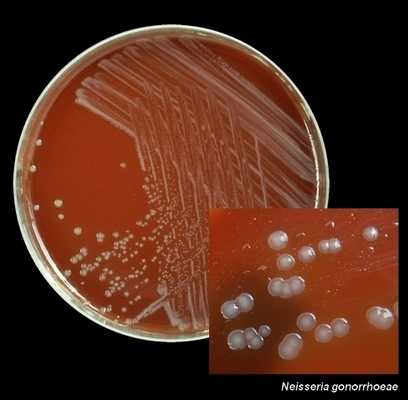
Колония гонококков на агаре

Гонорея. Возбудитель гонореи. Гонококк. Эпидемиология гонореи. Источник гонореи. Морфология гонококков. Тинкториальные свойства гонококков.
Добавил пользователь Владимир З. Обновлено: 01.01.2026
Гонококковая инфекция - инфекционное заболевание человека, вызываемое гонококками (Neisseria gonorrhoeae) - Грам-отрицательными диплококками, представляющими собой бобовидной формы, неподвижные, не образующие спор гноеродные бактерии /1,2/.
А54.0 Гонококковая инфекция нижних отделов мочеполового тракта без абсцедирования периуретральных или придаточных желез (цервицит, цистит, уретрит, вульвовагинит).
А54.1 Гонококковая инфекция нижних отделов мочеполового тракта с абсцедированием периуретральных или придаточных желез.
А54.2 Гонококковый пельвиоперитонит и другая гонококковая инфекция мочеполовых органов (Воспалительные заболевания органов малого таза - ВЗОМТ у женщин, эпидидимит, орхит, простатит).
А54.4 Гонококковая инфекция костно-мышечной системы (артрит, бурсит, остеомиелит, синовит, теносиновит).
А54.8 Другие гонококковые инфекции (абсцесс мозга, эндокардит, менингит, миокардит, перикардит, перитонит, пневмония, сепсис, поражение кожи).
А 54.9 Гонорея неуточненная
Пользователи протокола: дерматовенерологи, гинекологи, урологи, врачи общей практики, педиатры, терапевты.

Автоматизация клиники: быстро и недорого!
- Подключено 300 клиник из 4 стран
- 800 RUB / 4500 KZT / 27 BYN - 1 рабочее место в месяц

Автоматизация клиники: быстро и недорого!
- Подключено 300 клиник из 4 стран
- 1 место - 800 RUB / 4500 KZT / 27 BYN в месяц
Мне интересно! Свяжитесь со мной
Классификация
Диагностика
II. МЕТОДЫ, ПОДХОДЫ И ПРОЦЕДУРЫ ДИАГНОСТИКИ И ЛЕЧЕНИЯ
- Общеклиническое исследование урогенитального мазка (окраска метиленовым синим и/или по Граму) на другие ИППП (до начала терапии и после лечения 2 раза);
- Бактериологическое исследование биологического материала на Neisseria gonorrhoeae ручным методом (выделение чистой культуры) (до начала терапии и после лечения 2 раза);
- Бактериологическое исследование биологического материала на Neisseria gonorrhea на анализаторе (до начала терапии и после лечения 2 раза);
Минимальный перечень обследования, который необходимо провести при направлении на плановую госпитализацию: госпитализация не проводится.
Основные (обязательные) диагностические обследования, проводимые на стационарном уровне: госпитализация не проводится.
Дополнительные диагностические обследования, проводимые на стационарном уровне: госпитализация не проводится.
Диагностические мероприятия, проводимые на этапе скорой неотложной помощи: не проводится.
- болезненность при мочеиспускании (диспареуния), болезненность во время половых контактов (дизурия);
- дисфункциональные маточные кровотечения;
У более 50% женщин при поражении нижних отделов мочеполового тракта отмечается бессимптомное течение инфекции.
- учащенное мочеиспускание и ургентные позывы на мочеиспускание (при проксимальном распространении воспалительного процесса);
Как у женщин, так и мужчин при диссеминированной инфекции наблюдается симптомы общей интоксикации: повышение температуры тела; общая слабость и утомляемость; петехиальная (пустулезная) сыпь на коже; асиметричная артралгия и тендосиновит. Очень редко наблюдаются менингит или эндокардит.
У более 85% лиц обоего пола отмечается бессимптомное течение проктита, фарингита - у более 90%.
- гиперемия и отечность слизистой оболочки наружного отверстия мочеиспускательного канала, инфильтрация стенок уретры, слизистое или слизисто-гнойное уретральное отделяемое;
- гиперемия слизистой оболочки вульвы, влагалища; слизисто-гнойные выделения в заднем и боковых сводах влагалища и из цервикального канала.
Для детей характерна выраженная клиническая картина и многоочаговость поражения. У младенцев, рожденных инфицированными матерями, возможно инфицирование и развитие конъюнктивита.
- время, прошедшее с момента сексуального контакта (от 1 суток до 1 месяца (в среднем, 2-7 суток) с предполагаемым источником заражения
У женщин при этом поражаются наружные половые органы (половые губы, клитор), слизистая влагалища и шейки матки, полость матки, яичники, маточные трубы;
У мужчин поражается уретра, мочевой пузырь, предстательная железа, семенники, кожа полового члена, внутренний и наружный листок крайней плоти, мошонка, лобок, промежность;
У лиц обоего пола при гонорее инфицируются миндалины, слизистые полости рта, область ануса, прямая кишка.
- гиперемия и отечность слизистой оболочки наружного отверстия мочеиспускательного канала, инфильтрация стенок уретры, слизисто-гнойное или гнойное уретральное отделяемое;
- гиперемия и отечность слизистой оболочки вульвы, влагалища, слизисто-гнойные или гнойные выделения в заднем и боковых сводах влагалища;
- эндоцервикальные язвы, рыхлость и отек шейки матки, слизисто-гнойные или гнойные выделения из цервикального канала;
- гиперемия и отечность слизистой оболочки наружного отверстия мочеиспускательного канала, инфильтрация стенок уретры;
- увеличение и болезненность предстательной железы при пальпации.
- Общеклиническое исследование урогенитального мазка (окраска метиленовым синим и/или по Граму): обнаружение в биологическом материале Neisseria gonorrhea;
- Бактериологическое исследование биологического материала на Neisseria gonorrhoeae ручным методом (выделение чистой культуры): обнаружение в биологическом материале Neisseria gonorrhea;
- Бактериологическое исследование биологического материала на Neisseria gonorrhea на анализаторе: обнаружение в биологическом материале Neisseria gonorrhea;
- Определение гонококка в биологическом материале в реакции иммунофлюоресценции: обнаружение антигена и антител к Neisseria gonorrhea.
- Цистоуретроскопия: обнаружение воспалительной реакции слизистой уретры - эрозии, язвы, инфильтрация, стриктуры;
- Консультация неонатолога, педиатра - с целью уточнения объема и характера дополнительного обследования;
Дифференциальный диагноз
Дифференциальный диагноз проводят с другими специфическими урогенитальными инфекциями, обусловленными патогенными (C. trachomatis, T. vaginalis, M genitallium) и условно-патогенными микроорганизмами (грибы рода Candida, микроорганизмами, ассоциированными с бактериальным вагинозом) и вирусами (вирусом простого герпеса).
Лечение
Таблица 4. Антибактериальная терапия гонококкового уретрита, эндоцервицита, проктита, фарингита, конъюнктивита (взрослые и дети с массой тела > 45 кг)[6,7,8,9,10,11,12]:
Рекомендуемой и общепринятой тактикой лечения неосложненной гонореи нижних отделов мочеполовой системы является назначение АМП непосредственно во время первого визита пациента к врачу. При этом используются основные (выбора) схемы терапии, предусматривающие однократное применение антибиотика. Цефтриаксон в однократной в/м дозе 250 мг обеспечивает высокую и стойкую бактерицидную концентрацию в крови. Цефтриаксон является эффективным и безопасным препаратом для лечения неосложненной гонореи любой локализации (99,2% эффективность в терапии неосложненного уретрита и проктита; 98,9% - в терапии фарингита) [13,14].
Системную антибактериальную терапию можно сочетать с промыванием пораженного глаза стерильным физиологическим раствором [15].
- Цефиксим (таблетки 200, 400 мг); Спектиномицин (порошок для приготовления суспензии для в/м введения 2000 мг: фл. в компл. с растворителем);
- Цефотаксим (порошок для приготовления р-ра для в/в и в/м введения 500 и 1000 мг во флаконе).
Перечень дополнительных лекарственных средств (менее 100% вероятности применения): нет.
Терапия сопутствующей хламидийной инфекции у больных гонореей Пациенты, инфицированные гонореей, нередко бывают инфицированными C. trachomatis. В случае лабораторного подтверждения C. trachomatis как коинфекции, оправдано назначение азитромицина в терапии неосложненной гонореи в сочетании с неосложненным хламидиозом. Однако предпочтительным все же является назначение цефтриаксона и антибиотика из группы макролидов (препараты выбора) или доксициклина в соответствующих дозах [16,17,18].
Гонококковая инфекция у детей встречается крайне редко. Наиболее частой причиной ее развития у детей, преимущественно в препубертатном и пубертатном возрасте является сексуальное насилие.
Самым распространенным клиническим проявлением N. Gonorrhoeae у девочек доподросткового периода является вагинит. Воспалительные заболевания органов малого таза, вызванные N. Gonorrhoeae у детей встречаются значительно реже, чем у взрослых. У детей, подвергшихся сексуальному насилию, распространенными формами инфекции являются гонококковый проктит и фарингит, которые часто протекают бессимптомно.
Как указывалось ранее, для терапии гонореи у детей с массой тела более 45 кг следует использовать основные и альтернативные схемы терапии, рекомендованные для лечения гонореи у взрослых. Для терапии неосложненного гонококкового вульвовагинита, эндоцервицита, уретрита, фарингита и проктита у детей с массой тела менее 45 кг используют основную схему выбора:
При непереносимости к антибиотикам цефалоспориного ряда в качестве альтернативного антибиотика может использоваться:
В то же время эта схема может оказаться недостаточно эффективной при лечении гонококкового фарингита.
Цефтриаксон является антибиотиком выбора для терапии любых форм гонореи у детей. Другой антибиотик из группы цефалоспоринов третьего поколения цефотаксим может применяться только для лечения гонококкового конъюнктивита.
Все дети должны быть обязательно обследованы на сифилис и хламидийную инфекцию.
Инфекция, вызванная N. Gonorrhoeae у новорожденных возникает в результате контакта новорожденного с гнойным экссудатом шейки матки во время прохождения через родовые пути. Чаще болезнь протекает остро и проявляется клиническими симптомами уже на 2-5 сутки после рождения.
Распространенность гонореи у новорожденных коррелирует с распространенностью гонореи среди беременных, степени охвата их скринингом на инфекцию.
Наиболее тяжелыми проявлениями гонококковой инфекции у новорожденных являются офтальмобленнорея и сепсис, включая такие осложнения как артрит и менингит. К другим, менее тяжелым формам гонореи у новорожденных относятся вагинит, уретрит, ринит.
Несмотря на редкую встречаемость гонококкового конъюнктивита, новорожденных его своевременная терапия является особенно актуальной задачей, поскольку это заболевание может приводить к перфорации роговицы, а в конечном итоге - к полной потере зрения.
Новорожденные, которым не проводилась профилактика конъюнктивита в родильном доме и матери которых во время беременности не проходили медицинское обследование, относятся к группе повышенного риска развития офтальмобленнореи. В данную группу входят также те новорожденные, матери которых имеют в анамнезе ИППП, или злоупотребляют наркотиками.
Предварительный диагноз гонококкового конъюнктивита новорожденных, основанный на обнаружении в мазках отделяемого из конъюнктивы внутриклеточных грамотрицательных диплококков, является основанием для назначения эмпирической терапии. Целесообразность эмпирической терапии должна подтверждаться последующим обязательным выделением N. Gonorrhoeae из соответствующего клинического материала с определением чувствительности выделенных штаммов N. Gonorrhoeae к АМП. Одновременно эти новорожденные должны быть обследованы на C. trachomatis.
Превентивная терапия гонореи может быть рекомендована новорожденным из группы повышенного риска, а также новорожденным с конъюнктивитом, у которых в мазках отделяемого из конъюнктивы не обнаруживаются гонококки.
- Цефтриаксон в/м или в/в из расчета 25-50 мг/кг массы тела однократно. Максимальная доза препарата - 125 мг.
Проведение системной терапии цефтриаксоном у новорожденных с гонококковым конъюнктивитом не требует одновременного использования топического антибиотика, а назначение только местных форм АМП неэффективно.
При отсутствии клинического улучшения необходимо провести лабораторное обследование на наличие сопутствующей инфекции, вызванной C. trachomatis как у новорожденного, так и у его матери. Матери новорожденных больных гонореей, а также их половые партнеры должны пройти обследование, а при необходимости - и лечение в соответствие с рекомендациями по терапии гонореи у взрослых.
Новорожденным при отсутствии у них симптомов гонококковой инфекции, рожденных от матерей, больных гонореей и не получавших специфического лечения, следует провести превентивную терапию.
Дополнительного наблюдения за новорожденными, получивших превентивную терапию не требуется. И маму и новорожденного необходимо обследовать на C. trachomatis.
Матери новорожденных, больные гонореей и их половые партнеры должны пройти обследование, а при необходимости - лечение в соответствии с рекомендациями по терапии гонореи у взрослых.
Оптимальным методом профилактики инфекций, вызванных C. trachomatis и N. Gonorrhoeae у новорожденных является своевременное их выявление и лечение у беременных женщин. Новорожденным, родившимся от материей не обследованных на гонорею во время беременности проводятся профилактические мероприятия, включающие обработку очагов.
Каждый из рекомендуемых профилактических режимов позволяет предупредить развитие гонококкового конъюнктивита новорожденных. Рекомендованные средства профилактики:
Следует обработать оба глаза новорожденного сразу после родов. Если профилактика не была произведена в родильном зале, то ее обязательно следует провести в последующем как можно в более ранние сроки. При этом профилактика конъюнктивита осуществляется как детям, родившимся естественным путем, так и детям, родившимся путем кесарева сечения. Наиболее предпочтительным считается использование одноразовых пипеток или ампул.
Другие виды лечения: нет.
Хирургическое вмешательство: не проводится.
- Массовая профилактическая пропаганда, предусматривающая понятие личной и общественной профилактике ИППП через средства массовой информации, памятки и мультимедийные программы;
- Индивидуальные консультации и профилактические беседы с родителями и учащимися старших классов по вопросам межличностных отношений, полноценной информации о сексуальных отношениях, последствий раннего начала половой жизни, нежелательной беременности, разъяснение правил безопасного секса (применение презерватива);
- В кабинетах приема врачей дерматовенерологов, акушер-гинекологов, урологов, кабинетах профилактических осмотров на предприятиях, учебных организациях консультирование по способам предотвращения или снижения риска инфицирования гонококковой инфекцией и другими ИППП;
- Подготовка волонтеров, учащихся образовательных учреждений для проведения бесед о безопасном поведении и распространении литературы информационно-образовательного характера по вопросам профилактики ИППП [1].
- при подтверждении регресса клинических симптомов и отрицательных лабораторных результатах снятие с учета.
Гонорея. Описание заболевания.

Гонорея (от др.-греч. γόνος «семенная жидкость» и ῥέω «теку»; народное название - «триппер») — инфекционное заболевание, передаваемое половым путем.
Гонорея относится к венерическим заболеваниям и является одной из самых распространенных половых инфекций. Около 80% пациентов — сексуально активные люди молодого и среднего возраста.
Возбудителем этой болезни является болезнетворный микроорганизм - гонококк. Гонококки - это грамотрицательные бактерии, не образующие спор. Латинское название — Neisseria gonorrhoeae, по имени немецкого дерматовенеролога Альберта Нейссера (Albert Neisser), ставшего в 1879 году первооткрывателем.
Эпидемиология гонореи
Повсеместное распространение гонореи объясняется как повышением устойчивости гонококка к лекарствам (из-за их бесконтрольного приема), так и социальными факторами. В их числе - демографические изменения в человеческой популяции, рост числа случайных сексуальных контактов, проституция, гомосексуализм.
Следствием данных явлений также стали все более частые случаи выявления смешанных половых инфекций, в число которых входит и гонорея. В этих случаях могут изменяться клинические проявления заболевания, сроки инкубации, развитие осложнений и т. д.
Пути заражения и проявления гонореи
В большинстве случаев заражение происходит при сексе во влагалище или прямую кишку, но также возможна передача инфекции при оральных интимных ласках. Практически не происходит бытовое заражение гонореей, т.к. гонококк неустойчив во внешней среде и обычно быстро погибает вне человеческого организма.
Гонорея характеризуется поражением слизистых оболочек мочеполовых органов. В первую очередь, гонококками поражается слизистая оболочка урогенитального тракта (уретра, цервикальный канал). Сопротивляемость слизистых оболочек к возбудителю гонореи крайне низка.
У мужчин гонорея проявляется характерными симптомами. Гонококки, попадая на слизистые оболочки, восприимчивые к данной инфекции, вызывают воспалительную реакцию, которая сопровождается гнойными выделениями. У женщин гонорея часто протекает бессимптомно, вследствие чего заболевание может быть выявлено поздно, вызывая осложнения.
При осложнениях гонореи, человек может страдать от поражения уретры, предстательной железы, шейки матки, прямой кишки, глаз и полости рта.
Если заболевание имеется у беременной женщины, то заражение может передаваться и плоду при прохождении его по родовым путям во время родов, развивая у него гонококковый конъюнктивит, ринит, уретрит, вагинит, вульвовагинит, сепсис, менингит и др.
Классификация гонореи
Гонорею классифицируют по длительности заболевания и выраженности симптомов, а также по локализации и тяжести течения.
Свежая форма гонореи — заболевание имеет длительность до 2 месяцев от момента заражения. Клинически, течение свежей гонореи зависит от интенсивности реакции организма на внедрение возбудителя инфекции. Свежая форма подразделяется на острую, подострую и торпидную (бессимптомную).
Хроническая форма гонореи — это вялопротекающее заболевание, которое длится более 2-х месяцев или давность которого не установлена.
Кроме того, учитывают локализацию гонореи в тех или иных органах, наличие абсцессов и тяжелых осложнений. В зависимости от того, где локализуется патологический процесс, гонорею разделяют на генитальную, экстрагенитальную и диссеменированную (являющуюся осложнением двух первых). По тяжести течения различают неосложненную и осложненную гонорею.
Кроме того, существует латентная гонорея — это гонококконосительство, при котором вследствие несовершенства методов лабораторной диагностики не удается выявить возбудителей. При латентной гонорее у больных не выявляют ни клинических симптомов заболевания, ни гонококков. Эти больные могут быть источниками заражения т.к. они не знают о своем заболевании и не лечатся.
Гонорею важно лечить
Гонорею важно лечить! Несмотря на то, что данное заболевание не требует госпитализации и, при адекватном лечении, не представляет угрозу жизни пациента, оно представляет опасность для окружающих. Люди, заболевшие гонореей и не прошедшие лечения, в течение длительного времени являются переносчиками данной инфекции.
В последнее время ситуация с гонореей была взята под усиленных контроль, что позволяет эффективнее бороться с болезнью.
В Российской Федерации пациента с гонореей ставят на учет в кожно-венерологический диспансер на время лечения и контрольного наблюдения. При этом, больной сам имеет право выбора врача. Пациент может обследоваться в любом государственном или частном медицинском учреждении. После лечения необходим контроль излеченности в течение не менее 1 месяца. Если подтверждается регресс клинических симптомов и результаты лабораторных исследований отрицательные, то производится снятие с учета.
Определить наличие и решить вопрос о лечении данного заболевания вы можете в нашем Медицинском центре за 20 минут, т.к. диагностика проводится тест-системами последнего поколения. Ваше обращение в наш центр полностью анонимно. Первичную консультацию специалиста вы можете получить, обратившись в КАБИНЕТ №5.
Кроме того, вы можете получить консультацию и ответы на вопросы по указанным номерам телефона или по адресу электронной почты нашего Медицинского центра. Мы всегда рады помочь нашим пациентам с решением любой проблемы, независимо от её сложности!
Гонококк1
Возбудителя гонореи - инфекционного венерического заболевания с воспалительными проявлениями в мочеполовых путях открыл Альберт Нейссер в 1879 г. Первые культуры получили Лейстков и Леффлер (1882 г.), этиологическую роль доказал Бумм (1885).
Таксономия.
Семейство - Neisseriaceae Род - Neisseria Вид - N. gonorrhoeae
Морфология.
В свежих культурах гонококки представляют собой диплококки бобовидной формы, размером 1,25-1,0 х 0,7-0,8 мкм., образующие микрокапсулу. Жгутиков не имеют, спор не образуют. Хорошо окрашиваются анилиновыми красителями (метиленовым синим, бриллиантовым зеленым и др.). По Граму окрашиваются отрицательно. Образуют L- формы, в том числе и под действием пенициллина. Под влиянием химиопрепаратов могут быстро менять свойства и образовывать грамположительные формы. По наличию пилей гонококки разделяются на 5 типов. Ранее их обозначали Т1-Т5, сейчас Р + ,Р ++ , Р +++ … Бактерии типов Р + ,Р ++ снабжены нитями, имеют капсулу и вирулентны, бактерии прочих типов авирулентны.
В составе клеточной мембраны (стенки) содержится до 60 % белка I, на его основе осуществляется серотипирование гонококком методом ИФА. Кроме белка I, имеется белок II, который определяет специфичность клинических проявлений заболевания.
Культуральные свойства.
По типу дыхания - аэробы. Хемоорганотрофы. Требовательны к питательным средам. Растут на свежеприготовленных, влажных питательных средах с добавлением нативного белка (кровь, сыворотка, асцитическая жидкость). Оптимум рН 7,2-7,4; температуры - 37 0 С. Большинство свежевыделенныхштаммов для роста нуждаются в присутствии в атмосфере 4-10% СО2. При дальнейшем культивировании эти свойства утрачиваются.
На плотных питательных средах через 24 часа инкубирования гонококки, содержащие в клеточной стенке белок II, образуют прозрачные колонии в виде капелек росы (диаметром 1-3 мм) с ровным краем.
На жидких питательных средах растут диффузно и образуют поверхностную пленку, через несколько дней оседающую на дно.
Биохимическая активность.
Гонококки разлагают только глюкозу с образованием кислоты, образуют каталазу и цитохромоксидазу - типичные для нейссерий ферменты. Протеолитических свойств не имеют (аммиак, сероводород, индол не образуют), не вызывают гемолиза на кровяном агаре, на средах с добавлением молока, желатина и картофеля не растут.
Антигенная структура.
а) капсульные антигены;
в) белки клеточной оболочки - на их основании выделяют 16 антигенных серотипов;
Факторы патогенности.
Токсины. Гонококки не продуцируют экзотоксинов. Клеточная стенка содержит липополисахарид - эндотоксин, который оказывает токсическое воздействие.
- Структурные и химические компоненты:
а) капсула - обладает антифагоцитарным свойством, препятствует прямому контакту бактерицидных веществ с клеточной стенкой, маскирует ее антигенные детерминанты;
б) пили - обеспечивают адгезию гонококков к клеткам эпителия, что имеет решающее значение в развитии инфекции;
в) Ig А1 - протеаза. Гонококки синтезируют Ig А1 - протеазу, действующую внеклеточно и разрушающую пропин-треониновые связи в тяжелых цепях Ig, а также расщепляющую молекулу Ig в шарпирной части. Эти эффекты инактивируют антитела, препятствующие адгезии, что облегчает приклепление гонококков к рецепторам эпителиальных клеток, а также защищает их от фагоцитоза, опосредованного антителами;
г) способность к синтезу β - лактамаз.
Резистентность.
Гонококки неустойчивы во внешней среде, вне организма человека быстро погибают. При нагревании до 56 0 С гибнут за 5 мин., низкие концентрации перманганата калия (1:50) и нитрата серебра (1:10000), сулемы, карболовой кислоты губительно влияют на гонококков. Последние плохо переносят высушивание, УФЛ. Они чувствительны к антибиотикам (β - лактамные, аминогликозиды). Однако повышение заболеваемости гонореей связывают и с появлением пенициллинорезистентных штаммов гонококков.
Эпидемиология.
Источник инфекции - больной человек. Основной путь заражения - контактный половой, возможно инфицирование плода при прохождении через инфицированные родовые пути матери. Отмечены редкие случаи заражения при несоблюдении элементарных правил личной гигиены. Врожденная невосприимчивость отсутствует.
Роль в патологии
Гонококки вызывают гонореюу мужчин и женщин и являются возбудителями бленнореи новорожденных.
Патогенез
Гонорея - инфекционное венерическое заболевание, проявляющееся воспалением слизистых оболочек преимущественно половых путей. Термин гонорея (от греч. gone - семя, +rhoia - истечение) ввел К. Гален во II в. н.э. В настоящее время гонорея - одно из наиболее распространенных инфекционных заболеваний. Гонококки поражают, в основном, клетки цилиндрического эпителия. У новорожденных могут вызывать бленнорею (конъюктивит). При экстрагенитальной локализации могут поражать прямую кишку и миндалины.Они
прикрепляются к цилиндрическому эпителию уретры, влагалищной части шейки матки, прямой кишки, конъюктивы глаза, а также к сперматозоидам и простейшим (трихомонады, амебы). Адгезия происходит за счет пилей и белков наружной мембраны клеточной стенки. Характерной особенностью гонококков является их способность проникать в лейкоциты и размножаться в них. Липополисахаридная часть клеточной стенки бактерий оказывает токсическое действие на организм человека. Капсулярные полисахариды подавляют фагоцитоз. Соединяясь с ворсинками цилиндрического эпителия слизистой уретры, а у женщин - и эндоцервикального канала, гонококки проникают внутрь клетки при участии белков наружной мембраны клеточной стенки. Это приводит к развитию острого уретрита, цервицита и поражению у женщин шейки матки, воспалению придатков (трубы, яичники), у мужчин происходит воспаление семенных семенных пузырьков, предстательной железы.
Иммунитет.
После перенесенного заболевания иммунитет не вырабатывается. Врожденная невосприимчивость к гонорее отсутствует, возможны супер- и реинфекции. Единственный чувствительный организм - человек. До сих пор остается неясным вопрос, почему антитела, определяемые в сыворотке больного (агглютинины, преципитины, опсонины), не обеспечивают защиту от повторного заражения.
Профилактика. Средства специфической иммунопрофилактики отсутствуют, что обусловлено высокой антигенной изменчивостью гонококков. Гоновакцина, на которую возлагалось много надежд, оказалась неэффективной. Общая профилактика основана на мерах предупреждения венерических заболеваний. Для предупреждения гонобленореи новорожденным сразу после рождения закапывают в конъюктивальный мешок (девочкам также в половую щель) 1-2 капли раствора сульфацила натрия или антибиотика (пенициллины, цефалоспарины)
Лечение.
Основу терапии составляет антимикробная терапия. Препараты выбора - сульфаниламиды и антибиотики, подавляющие жизнедеятельность гонококков (β - лактальные антибиотики, аминогликозиды). Для лечения хронических или осложненных форм гонореи используют гоновакцину.
Микробиологическая диагностика.
Наиболее распространенным методом является бактериоскопическое исследование. Выделение чистой культуры проводится сравнительно редко, главным образом, при хронической гонорее, когда бактериоскопия дает отрицательный результат. Кроме того, в настоящее время используют РИФ и ПЦР. Серодиагностика при хронической гонорее (РСК) проводится редко
Возбудитель гонореи.
Гонорея - инфекционное венерическое заболевание с гнойным воспалением слизистых оболочек мочеполовых органов. Характеристика возбудителя. Возбудитель гонореи -гонококк -Neisseriagonorrhoeae. Относится к семNeisseriaceae, отд. Сгасi1icutes.Морфология: диплококк бобовидной формы, неподвижен, споры не имеет, не образует капсулы. В мазке из гноя располагается внутри лейкоцитов (незавершенный фагоцитоз).
Тинкториальные свойства: грам”-”. Культуральные свойства: аэроб или факультативный анаэроб. Не растет на простых средах. Выращиваетсяна средах с кровью или сывороткой. Растет на средах с ристомицином или полимиксином. Образует мелкие, круглые, прозрачные колонии. Оптимальная температура — 37С (при температуре 25С не растет).
Биохимические свойства слабые. Расщепляет только глюкозу до кислоты. Белки не расщепляет. Имеет цитохромоксидазу.
Антигенная структура изучена плохо. Имеет белковый антиген, общий с менингококками,и полисахаридный антиген, по которому различают серовары.
Факторы патогенности: эндотоксин -токсическая субстанция клеточной стенки -липополисахарид.
Резистентность: гонококки малоустойчивы во внешней среде. Высокочувствительны к высушиванию, температуре, дез. средствам.
Эпидемиология гонореи. Гонореей болеет только человек. Ни один вид животных в естественных и экспериментальных условиях не восприимчив к гонококку.Источник инфекции —больной человек.
Пути передачи: 1) половой контакт — основной путь; 2) через инфицированные предметы обихода — при пользовании общими с больным человеком постелью, полотенцем, бельем, мочалкой; редко. Заражение новорожденных бленореей (воспаление слизистой оболочки глаз) происходит через инфицированные родовые пути матери. Уровень заболеваемости связан с социальными условиями. Война, безработица, проституция способствуют распространению инфекции.
Инкубационный период -2 - 4 дня. Наблюдается острое гнойное воспаление уретры, половых желез, шейки матки у женщин, семенных пузырьков, предстательной железы у мужчин. Приострой гонорее наблюдается зуд в мочеиспускательном канале, резь при мочеиспускании, выделение из уретры жидкого гноя желто-зеленого цвета. Отмечается гиперемия и отечность половых органов.Хроническая гонореи протекает более спокойно и вяло: гнойные выделения более скудные, слабее выражены зуд и резь. Однако больные, как и при острой гонорее, являются заразными. При отсутствии лечения или нарушении режима лечения развиваются осложнения: воспаление яичников, простаты, семенных пузырьков, суставов, сужение мочеиспускательного канала, нередко бесплодие уженщин и мужчин. Гонококки могут проникать в прямую кишку, вызывать эндокардиты, менингиты, артриты, стоматиты, конъюнктивиты.
Иммунитет. Перенесенное заболевание не оставляет иммунитета. Возможны повторные заражения.
Лабораторная диагностика. Исследуемый материал: отделяемое уретры, влагалища, шейки матки, предстательной железы, прямой кишки, моча, сперма.Методы: 1) бактериоскопический — основной метод диагностики: мазки окрашивают по Граму и метиленовым синим (фагоцитоз незавершен); хороший метод —люминесцентная микроскопия после обработки мазков флюоресцирующими антителами против гонококков (зеленое свечение); 2) бактериологический — используется при отсутствии результатов микроскопии; 3) серологический метод — прихронической гонорее — обнаружение антител в сыворотке больного к гонококковому антигену; для этого используетсяРСК —реакция Борде-Жангу.
Лечение. Приострой гонорее применяются антибиотики: пенициллин, стрептомицин, тетрациклин, а также сульфаниламиды. Ранее их применение обеспечивает излечение. Используется местное лечение — промывание уретры раствором ляписа, раствором перманганата калия (1:5000). Во время лечения из диеты исключаются острые блюда, алкогольные напитки, физические нагрузки. Прихронической гонорее проводится вакцинотерапия. Используетсяубитая гоновакцина (из 12 штаммов) иаутовакцина. Проводят аутогемотерапия и пиротерапию (введение продигиозана, чужеродных протеинов).
Профилактика. Спецпрофилактика отсутствует. Общая профилактика - меры, используемые для профилактики венерических заболеваний: санитарно-гигиенические мероприятия, санитарно-просветительная работа среди населения, здоровый образ жизни, выявление и лечение больных гонореей, исключение случайных половых связей. Использование презервативов, обследование групп риска. Законом предусматривается наказание за уклонение от лечения и заведомое заражение других лиц.
Гонококк - возбудитель гонореи

Латинское название этого микроорганизма — Neisseria gonorrhoeae, по имени немецкого дерматовенеролога Альберта Нейссера (Albert Neisser), который впервые описал гонококки в 1879 году.
Гонококки относятся к диплококкам - то есть имеют округлую форму (кокки) и обычно встречаются парами.
Под микроскопом гонококки представляют собой неподвижные бактерии бобовидной или кофейной формы, обращенные друг к другу вогнутой поверхностью. В сканирующем электронном микроскопе гонококки имеют вид шаровидных или диплококковых образованией со слегка бугристой поверхностью. Их длина составляет от 1.25 — 1.6 мкм, поперечные размеры — 0.7- 0.8 мкм. Гонококки хорошо окрашиваются всеми анилиновыми красителями.
В процессе изучения тончайших срезов данных бактерий, у них выявлена клеточная стенка, цитоплазматическая мембрана, цитоплазма с рибосомами, мезосомы и нуклеотид с нитями ДНК. На поверхности гонококков выявлены тонкие трубчатые нити (пили), которые помогают возбудителю проникать в организм и обеспечивают ряд других биологических свойств. В частности, пили играют заметную роль роль в передаче генетической информации, например об устойчивости к антибиотикам.
Гонококки растут на искусственных питательных средах в присутствии человеческого белка (асцитический агар) при температуре 37 °С.
Колония гонококков на агаре
Гонококки выявленные в отделяемом уретры отличаются по строению от полученных путем выращивания на агаре. Например, при пересевах гонококков на искусственные питательные среды, бактерии довольно быстро утрачивают пили.
У ряда штаммов гонококков, эти микроорганизмы снаружи окружены капсулой из полисахаридов, что позволяет им избежать поглощения и разрушения лейкоцитами.
Важнейшим свойством гонококка является антигенная изменчивость. Это означает, что у этих бактерий постоянно меняются антигенные детерминанты. Т.е. с каждой сменой популяции и даже на протяжении периода жизни одной популяции гонококков, происходит и смена их антегенной структуры. Частично это связано с тем, что основную антигенную нагрузку несут пили и поверхностные белки клеточной стенки, а также со способностью гонококков к взаимной передаче генетической информации.при непосредственном контакте двух клеток.
Под влиянием ряда факторов, в первую очередь антибиотиков, гонококки могут менять форму, способность воспринимать окраску и биологические свойства.
Иногда гонококки трансформируются в так называемые «L-формы» — шаровидные, имеющие различную величину и окраску. L-формы весьма устойчивы по отношению к негативным воздействиям. Утратив часть своих антигенных свойств, они становятся нечувствительными к антителам и лекарственным препаратам, вызвавшим их образование. Сохранение в организме L-форм затрудняет диагностику и лечение гонореи, способствует способствует выживанию инфекции в организме и возникновению рецидивов.
Вне человеческого организма гонококки быстро погибают. На них губительно действуют антисептические препараты, мыльные растворы, высушивание или прямые солнечные лучи.
Гонококки не переносят нагревание до температур свыше 56°С; при 42°С гонококки погибают за 5-15 часов. Быстрее всего гонококк гибнет при воздействии ультрафиолетового облучения и инсоляции (за 30-60 минут). Температуру ниже оптимальной гонококки также переносят плохо и быстро погибают при 18 °С.
Гонококк может длительно сохранять жизнеспособность после высушивания из замороженного состояния; длительно переносит замораживание (-20-70°С), но гибнет при повторном замораживании и оттаивании.
Читайте также:
